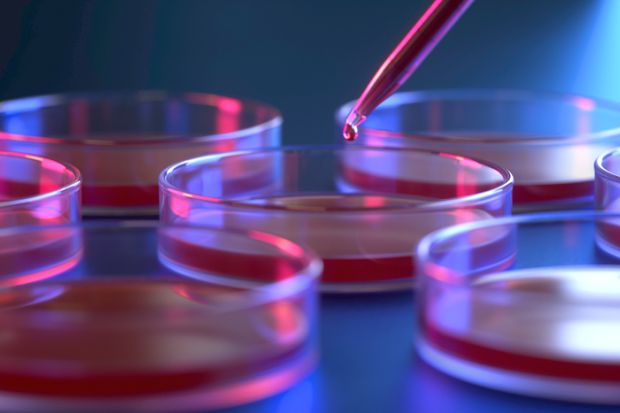

Scientists who raised the possibility of a Chinese lab leak origin for the Covid pandemic have been labelled “anti-scientific” conspiracy theorists by the rest of the community, according to the co-author of a recent book on the subject.
The House of Commons Science and Technology Committee heard from Alina Chan, a postdoctoral associate molecular biologist at the Broad Institute of MIT and Harvard, during a hearing on reproducibility and research integrity on 15 December.
Dr Chan is co-author, alongside Conservative peer Viscount Ridley, of Viral: The Search for the Origin of Covid-19 – which one reviewer has described as offering no evidence for manufacturing of the virus and being “highly misleading” in its claims on genetic mutations.
The hearing’s section on the role of journal publication in the early stages of the pandemic and in relation to suggestions the Wuhan outbreak could have been caused by a leak from the Wuhan Institute of Virology began with questions to Richard Horton, editor-in-chief of medical journal The Lancet, which in February 2020 published a letter by a group of scientists who wrote to “strongly condemn conspiracy theories suggesting that COVID-19 does not have a natural origin”.
The Lancet has been criticised over the fact that at the time there was no disclosure that one of the signatories to the letter, Peter Daszak, president of research funder the EcoHealth Alliance, had for years funded and worked with Wuhan Institute of Virology researchers to collect bat coronaviruses from the wild. The journal added a competing interests statement to the letter in June 2021.
Conservative MP and committee member Aaron Bell asked whether the letter published by The Lancet had served “to close down scientific debate prematurely”.
Dr Horton said that in the early stages of the pandemic there had been a “blame game”. He added: “The purpose of the letter was to say, ‘Let’s make common cause with our Chinese colleagues to try to get to the bottom of the origins of the pandemic.’”
The World Health Organisation’s March 2021 report had been a “turning point in backing that [lab leak] hypothesis, with three others, as a candidate for serious investigation”, he continued.
Dr Horton also said: “I would agree with the WHO conclusion that it’s a hypothesis that should be taken seriously and needs to be further investigated – but they have deemed that hypothesis extremely unlikely compared with infection through an intermediate zoonotic host, which they have deemed much more likely.”
Dr Chan told the committee: “The Lancet really needs to publish all of the manuscripts it received…withdrawn or rejected by the journal; we need to see what you received from Chinese scientists in the early days of the pandemic. We know from Jeremy Farrar’s book that The Lancet was in possession of information of human-to-human transmission of this virus, pre-symptomatic transmission of this virus, and you did not release that to the world. This could have led to many more lives saved if it had been released to the world.”
Dr Horton said later in the hearing that communications with authors were confidential and would remain so.
Lord Ridley told the committee of the lab leak theory: “It is regrettable that in 2020 there was a pretty systematic attempt to shut down this topic.”
Asked about death threats against her, Dr Chan said: “I’m not in a rare situation – a lot of scientists [working on Covid issues] have suffered abuse.”
She added: “But in this situation specifically there are potential career effects. So for a scientist to come out and say something the rest of the community doesn’t want to talk about, has condemned as a conspiracy theory since early 2020, has said that anybody raising the possibility of a lab origin is anti-scientific, is racist, is a right-winger – that’s crazy.”
Register to continue
Why register?
- Registration is free and only takes a moment
- Once registered, you can read 3 articles a month
- Sign up for our newsletter
Subscribe
Or subscribe for unlimited access to:
- Unlimited access to news, views, insights & reviews
- Digital editions
- Digital access to THE’s university and college rankings analysis
Already registered or a current subscriber?